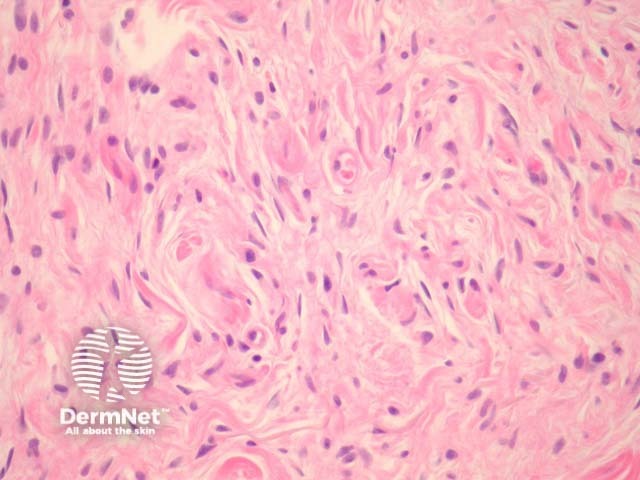
Figure 3
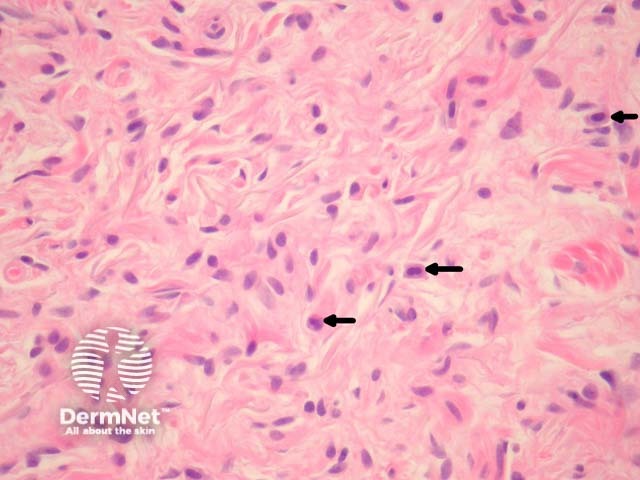
Figure 4

Main menu
Common skin conditions
NEWS
Join DermNet PRO
Read more
Quick links
Lesions (benign) Diagnosis and testing
Author: Assoc Prof Patrick Emanuel, Dermatopathologist, Auckland, New Zealand, 2013.
Neurofibromas are common tumours that may occur either as a solitary lesion or in multiplicity (neurofibromatosis).
In a neurofibroma, sections show a non-encapsulated lesion in the dermis (figure 1). These lesions represent a proliferation of all elements of peripheral nerves. The cells have wavy serpentine nuclei and pointed ends (figures 2-4). There is stromal mucin deposition and fibroplasia (figures 2-4). Mast cells are usually easy to find (figure 4, arrow). Axons course through the tumour and though difficult to see on routine sections may be illustrated with immunohistochemical stains for neurofilament.
Plexiform neurofibroma is a subtype in which the tumour grows within and irregularly expands a nerve bundle. Though large plexiform neurofibromas are thought to be diagnostic of NF1, a plexiform pattern may be seen in solitary skin lesions that are of little clinical significance.

Figure 1

Figure 2
Figure 3
Figure 4
Positive stains: S100, CD34+ (focal)
Negative stains: EMA (except in plexiform neurofibromas in which EMA stains the surrounding perineurium of the nerve bundle).
Schwannoma – Shows Antoni A and B pattern and is encapsulated. Plexiform neurofibroma may resemble schwannoma. Neurofibromas typically have axons coursing through the mass, which stain with neurofilament immunohistochemically.
Perineurioma – These are EMA positive and S100 negative.
Dermatofibromasarcoma protuberans – These are positive with CD34, and lack S100 positivity.